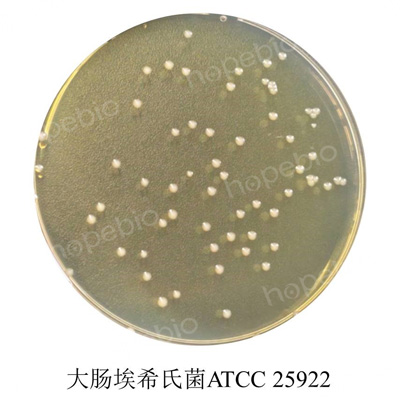

海博微信公众号
海博微信公众号
 海博天猫旗舰店
海博天猫旗舰店


 海博微信公众号
海博微信公众号
 海博天猫旗舰店
海博天猫旗舰店




一、试验原理
用途:用于培养大肠埃希氏菌K88和K99987P菌株,能产生高单位的纤毛抗原,制三价灭活苗效力良好。
原理:胰蛋白胨、酵母浸粉提供碳氮源、维生素和生长因子;磷酸二氢钾和磷酸氢二钠为缓冲剂;硫酸镁、氯化锰、氯化亚铁、氯化钙提供微量元素。
二、培养基配方:
略
三、试验方法
1、称取本品15.4g,另取甘油5mL,加热溶解于1000mL蒸馏水中,116℃高压灭菌30min,备用。
2、制备质控菌株,做10倍系列稀释,选择适宜稀释度的菌悬液,接种于待测培养基和参比培养基(HB0177-8胰蛋白胨大豆琼脂(TSA)),并做空白对照。
3、放置于36℃恒温培养箱中,需氧培养18h-24h。
四、质控结果
接种以下质控菌株,放置于36℃恒温培养箱中,需氧培养18h-24h。试验结果如图所示。
|
质控菌株 |
菌株编号 |
接种量(CFU) |
参比或计数培养基 |
质控结果 |
其它特征 |
|
大肠埃希氏菌 |
ATCC 25922 |
10-100 |
TSA |
生长良好 |
浑浊 |
质控菌株菌悬液在TSA上的计数结果

图1 改良Minca肉汤培养基的质控菌株培养结果
五、注意事项
培养基中含少量金属离子等,灭菌后可能出现微量沉淀。
相关产品:
注:本文属海博生物原创,未经允许不得转载。
| 相关文章: | ||



